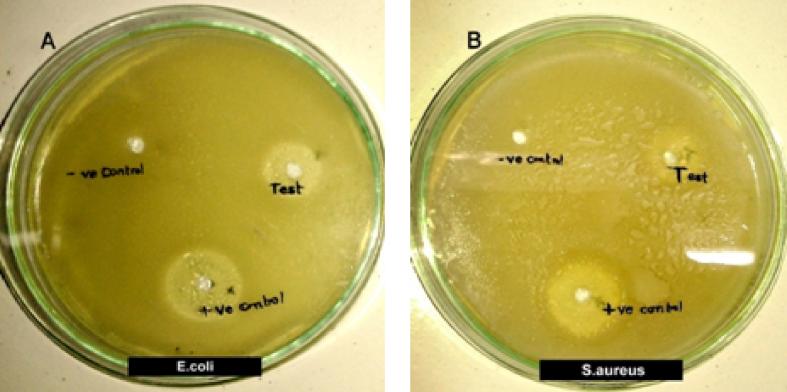
https://cdn.ncbi.nlm.nih.gov/pmc/blobs/120d/6992982/933307ce3b82/gr3.jpg

交联海藻酸盐作为绿色包装材料的合成、表征及应用
Synthesis, characterization and application of crosslinked alginate as green packaging material.
作者信息
Singh Pratiksha, Baisthakur Pankaj, Yemul Omprakash S
机构信息
School of Chemical Sciences, Swami Ramanand Teerth Marathawada University, Nanded, Maharashtra, 431 606, India.
School of Life Sciences, Swami Ramanand Teerth Marathawada University, Nanded, Maharashtra, 431 606, India.
出版信息
Heliyon. 2020 Jan 23;6(1):e03026. doi: 10.1016/j.heliyon.2019.e03026. eCollection 2020 Jan.
Plastic films for food wrapping, packing are widely used due to their special properties. These fossil fuel derived films are associated with long degradation time, toxicity and environmental pollution. Pineapple waste, sea weed can be very good renewable, alternative carbon sources to produce edible films. These edible films can be consumed by lower animals thereby overcoming the disposal problems of accumulating waste plastic and hence reducing pollution. In the present study, crosslinked polymers are prepared from pectin (P)/sodium alginate (SA) through crosslinking with bio-based acids such as citric acid (CA) and tartaric acid (TA). Pectin was extracted from waste pineapple shell and sodium alginate extracted from seaweed. The crosslinked films were characterized by using various analytical techniques such as FT-IR, thermogravimetry, and scanning electron microscopy (SEM). Mice feed study (testing of edibility), plant growth substrate and vermicomposting of these films was studied. Finally a suitable application of these newly prepared polymeric films has been evaluated as wrapping material on food products such as chocolate and Indian vegetable puff to enhance the shelf life of food.
用于食品包装的塑料薄膜因其特殊性能而被广泛使用。这些源自化石燃料的薄膜具有降解时间长、毒性和环境污染等问题。菠萝废料、海藻可以成为非常好的可再生替代碳源,用于生产可食用薄膜。这些可食用薄膜可被低等动物食用,从而克服了废弃塑料堆积的处置问题,进而减少污染。在本研究中,通过与生物基酸如柠檬酸(CA)和酒石酸(TA)交联,由果胶(P)/海藻酸钠(SA)制备了交联聚合物。果胶从废弃菠萝壳中提取,海藻酸钠从海藻中提取。通过使用各种分析技术如傅里叶变换红外光谱(FT-IR)、热重分析和扫描电子显微镜(SEM)对交联薄膜进行了表征。研究了这些薄膜的小鼠饲料研究(可食用性测试)、植物生长基质和蚯蚓堆肥。最后,对这些新制备的聚合物薄膜作为巧克力和印度蔬菜泡芙等食品的包装材料进行了评估,以延长食品的保质期。